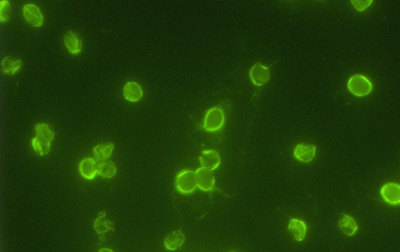

Kryptosporidien: Nicht nur bei Immunsuppression relevant
Kryptosporidien sind weltweit verbreitet. Bekannt sind mittlerweile mindestens vierundvierzig Spezies, die größtenteils auch Haus- und Wildtiere infizieren können; Cryptosporidium hominis wird jedoch fast ausschließlich beim Menschen gefunden. Neben C. hominis wird vor allem C. parvum beim Menschen nachgewiesen.
PROF. DR. MED. RALF IGNATIUS
Die Erreger kommen in zwei verschiedenen Formen vor: Die ausgesprochen umweltstabilen Oozysten (sie sind auch resistent gegenüber der Trinkwasserchlorung!) dienen der Weiterverbreitung, während im Dünndarm die sexuelle und asexuelle Vermehrung der Erreger durch die vegetativen Formen erfolgt. Der Mensch steckt sich meist über mit Oozysten kontaminierte Nahrungsmittel oder Trinkwasser an; Ausbrüche sind nicht selten. Eine weitere Infektionsquelle liegt im akzidentellen Verschlucken von Wasser beim Baden oder Schwimmen in Seen.
Cryptosporidium parvum (Public Domain, Wikimedia Commons)
In Deutschland ist die Kryptosporidiose nach der Giardiasis die zweithäufigste meldepflichtige Parasitose mit einer erhöhten Anzahl gemeldeter Fälle in der Zeit von Juli bis November. Das RKI gibt für 2020 eine Inzidenz von 1,4 Erkrankungen/100.000 Einwohner an, was im Vergleich mit den vorherigen 5 Jahren einen pandemiebedingten Rückgang um 36 % bedeutete; 1.190 Meldungen erfüllten die RKI-Falldefinition. Die geographische Verteilung zwischen den einzelnen Bundesländern variierte dabei erheblich (siehe Abb. 1). Im selben Jahr wurden 13 Ausbrüche mit insgesamt 32 Patienten gemeldet.

Abbildung 1. Übermittelte Kryptosporidiosen pro 100.000 Einwohner nach Bundesland, Deutschland, 2020 (n = 1.190) im Vergleich mit den Vorjahren.
Die höchsten altersspezifischen Inzidenzen wurden bei 1- bis 9-jährigen Kindern gesehen (siehe Abb. 2). Diese Altersverteilung verdeutlicht, dass die häufige Annahme, dass Kryptosporidien vor allem immungeschwächte Patienten infizieren, nicht zutrifft. Sowohl bei Kindern als auch bei Erwachsenen waren Mädchen bzw. Frauen häufiger infiziert als Jungen bzw. Männer, wobei vor allem bei Erwachsenen von einer deutlichen Untererfassung auszugehen ist. Die meisten Kryptosporidiosen werden in Deutschland erworben. Es kommen jedoch auch reiseassoziierte Infektionen vor, deren Anteil an der Gesamtzahl der Infektionen im Jahr 2020 allerdings pandemiebedingt vergleichsweise gering war.

Abbildung 2. Übermittelte Kryptosporidiosen pro 100.000 Einwohner nach Alter und Geschlecht, Deutschland, 2020 (n = 1.190).
Nach einer Inkubationszeit von 7 bis 10 (1 bis 12) Tagen entwickelt sich in Abhängigkeit vom Immunstatus ein variables Krankheitsbild. Immungesunde können selbstlimitierte akute Durchfälle und abdominelle Beschwerden, gelegentlich auch Fieber entwickeln; asymptomatische Infektionen kommen ebenfalls vor. Bei Immunsupprimierten, v. a. AIDS-Patienten, können chronische Diarrhoen mit zum Teil erheblichen Flüssigkeits- und Elektrolytverlusten entstehen, die zum Tode führen können. Malabsorption und Befall der Gallenwege können ebenfalls auftreten.
Die Labordiagnose erfolgt über den Erregernachweis im Stuhl, wobei die Erreger aufgrund ihrer geringen Größe (4–6 µm) in der einfachen lichtmikroskopischen Untersuchung auf Parasiten und Wurmeier nicht erkannt werden können. Der Nachweis mittels PCR ist sensitiver als die lichtmikroskopische Untersuchung nach säurefester Färbung oder der Nachweis parasitärer Antigene und wurde aus diesem Grund 2022 in den EBM aufgenommen. Sämtliche Erregernachweise in Verbindung mit einer akuten Infektion sind meldepflichtig.
Neben einer primär symptomatischen Therapie mit Rehydratation und ggf. Motilitätshemmern können als antiparasitäre Medikamente Paromomycin, Albendazol, Azithromycin oder das in Deutschland nicht zugelassene Nitazoxanid eingesetzt werden, wobei für alle genannten Wirkstoffe die Studienlage unzureichend ist. HIV-Patienten profitieren von einer retroviralen Therapie und der damit verbundenen Verbesserung des Immunstatus.
---
Literatur
- Robert Koch-Institut. RKI-Ratgeber Kryptosporidiose. www.rki.de/DE/Content/Infekt/EpidBull/Merkblaetter/Ratgeber_Kryptosporidiose. html#doc2398518bodyText3
- Robert Koch-Institut. Infektionsepidemiologisches Jahrbuch meldepflichtiger Krankheiten für 2020, Berlin 2021